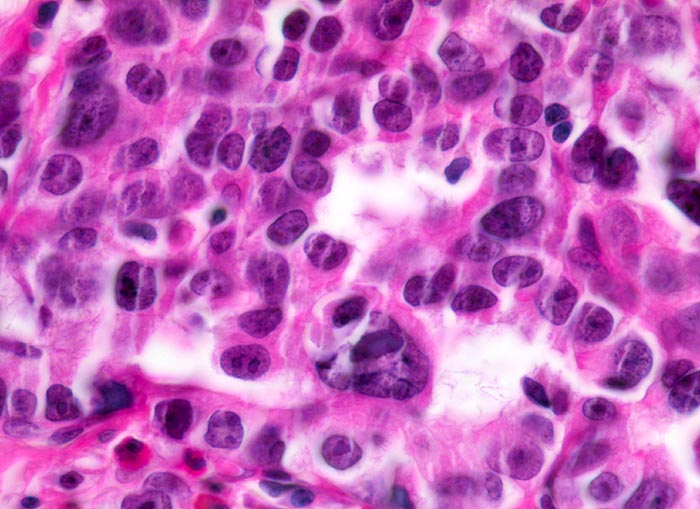

PathoPic – image database / PathoPic ID 5056 - Adenokarzinom intestinaler Typ nach Lauren
de
Diagnose
Adenokarzinom intestinaler Typ nach Lauren
Diagnose Gruppe
maligner Tumor
Topographie
Magenantrum
Topographie Gruppe
Oesophagus, Magen
Beschreibung
Atypische Zellen bilden tubuläre Strukturen. Die Malignität lässt sich an den stark vergrösserten, polymorphen, hyperchromatischen Kernen mit prominenten und irregulär geformten Nukleolen ablesen.
Zusatzbefund
Polypoider Tumor im Magenantrum.
Klinik
Endoskopische Kontrolle bei Patient mit bekannter chronischer Gastritis.
Bilder Typ
Histologie
Vergrösserung
630
Alter
68
Geschlecht
unbekannt
Datum
Ersteintrag: 05.07.2002